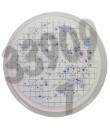
Milieu easydry sabouraud dextrose pour determination champignon 100 pcs

Laboratoire
449561 produits - Trié par pertinence
Milieu déshydraté modified rappaport soy (m.r.s.v) 500 g
Réf. UGAP : 3658737 Réf. constructeur : 1376
Milieu easydry sabouraud dextrose pour determination champignon 100 pcs
Réf. UGAP : 3664412 Réf. constructeur : 87510
Milieu préparé en flacon 100ml gelose bile violet glucose 10 flacons
Réf. UGAP : 3658754 Réf. constructeur : 5158
Milieu synthétique minimal pour levure (sd) -trp -leu +agar (5 l)
Réf. UGAP : 3629247 Réf. constructeur : 630317
Mineral oil light white high purity gr 100 ml
Réf. UGAP : 3635040 Réf. constructeur : VWRVJ217-100ML
Mitochondria Isolation Kit mouse tissue/for 25 separations
Réf. UGAP : 3729901 Réf. constructeur : 130-096-946
Mitochondrial brown fat uncoupling protein 1 (ucp1) 96 tests
Réf. UGAP : 3681992 Réf. constructeur : AE59448RB-96
Mix-n-stain maxi cf488a antibody labeling kit, 1x1 mg labeling 1 kit
Réf. UGAP : 3656427 Réf. constructeur : 92405